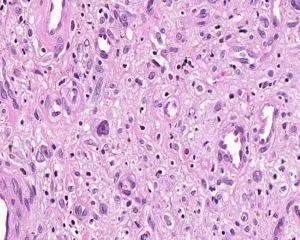
blog-1-1 blog-1-1

Resveratrol powder, a potent antioxidant found predominantly in red grapes and their derivatives, has been making waves in the skincare industry. This remarkable compound, with its chemical formula C14H12O3, is revolutionizing how we approach skin health and anti-aging. But what exactly does resveratrol do for your skin? Let's delve into the science behind this skincare superstar and uncover its multifaceted benefits.

Product Name:Resveratrol(Res)
Chemical formula: C14H12O3
CAS No.:501-36-0
Specifications :Resveratrol ,Min 50%, Min 98%,HPLC
Appearance: White to light yellow powder, odorless
Solubility: Hardly soluble in water, but easily soluble in organic solvents such as ether, methanol, acetone, ethyl acetate, etc
Efficacy: Anti-oxidation, anti-inflammatory, cardiovascular protection, anti-cancer, immunity enhancement. Resveratrol also has multiple biological activities such as antibacterial, anti-asthma, anti-obesity, nerve protection, and anti-aging
Collagen Boost: Resveratrol's Secret Weapon
One of the most significant ways resveratrol benefits your skin is through its ability to boost collagen production. Collagen, the protein responsible for maintaining skin's structure and elasticity, naturally decreases as we age. This reduction leads to the formation of wrinkles and sagging skin. Resveratrol comes to the rescue by stimulating the production of collagen, helping to maintain skin's youthful appearance.
Stimulating Fibroblasts
Resveratrol works its magic by activating fibroblasts, the cells responsible for producing collagen. By enhancing fibroblast activity, resveratrol encourages the skin to produce more collagen, resulting in firmer, more elastic skin. This process helps to reduce the appearance of fine lines and wrinkles, giving your skin a more youthful and radiant look.

Protecting Existing Collagen
In addition to boosting collagen production, resveratrol powder also protects existing collagen from breakdown. It does this by inhibiting enzymes that degrade collagen, such as matrix metalloproteinases (MMPs). By preserving the collagen already present in your skin, resveratrol helps maintain skin structure and firmness over time.
Enhancing Skin Elasticity
The collagen-boosting properties of resveratrol translate directly to improved skin elasticity. As collagen levels increase, skin becomes more resilient and better able to bounce back from stretching or compression. This enhanced elasticity contributes to a more youthful, supple appearance and helps prevent the formation of new wrinkles.

Antioxidant Power: Protecting Skin from Free Radicals
Resveratrol's potent antioxidant properties are another key factor in its skin-benefiting arsenal. As a powerful antioxidant, resveratrol neutralizes harmful free radicals that can damage skin cells and accelerate the aging process. This protection is crucial for maintaining healthy, youthful-looking skin.
Combating Oxidative Stress
Free radicals, unstable molecules that can damage cellular structures, are a major contributor to skin aging. They're produced naturally by our bodies but are also generated by external factors like UV radiation, pollution, and stress. Resveratrol acts as a scavenger, neutralizing these free radicals before they can cause harm. This action helps prevent oxidative stress, which can lead to premature aging, dark spots, and uneven skin tone.

UV Protection
While not a substitute for sunscreen, resveratrol powder has been shown to offer some protection against UV damage. It helps to neutralize the free radicals generated by UV exposure and may even enhance the efficacy of topical sunscreens. This added layer of protection can help prevent sun-induced skin damage, including premature aging and hyperpigmentation.

Reducing Inflammation
Resveratrol also exhibits potent anti-inflammatory properties. Chronic inflammation in the skin can lead to various issues, including accelerated aging, acne, and skin sensitivity. By reducing inflammation, resveratrol helps soothe irritated skin, reduce redness, and promote overall skin health.

Resveratrol serum application tips for glowing skin
To maximize the benefits of resveratrol for your skin, it's essential to use it correctly. Here are some tips for incorporating resveratrol into your skincare routine:
Choose the Right Product
When selecting a resveratrol product, opt for serums or moisturizers with a concentration of at least 1% resveratrol. Look for products that combine resveratrol with other antioxidants like vitamin C or E for synergistic effects. Remember, resveratrol is sensitive to light and air, so choose products packaged in opaque, air-tight containers to maintain potency.
Application Technique
Apply your resveratrol serum to clean, slightly damp skin. This allows for better absorption. Gently pat the product into your skin rather than rubbing, which can cause irritation. Focus on areas prone to signs of aging, such as around the eyes, forehead, and mouth.
Timing is Key
For optimal results, use your best resveratrol powder product at night. This is when your skin's natural repair processes are most active, allowing the resveratrol to work in synergy with your skin's regeneration cycle. If using during the day, always follow with a broad-spectrum sunscreen to protect your skin from UV damage.
Consistency is Crucial
Like most skincare ingredients, the benefits of resveratrol are cumulative. Consistent use over time will yield the best results. Incorporate resveratrol into your daily skincare routine and be patient – it may take several weeks to see noticeable improvements in your skin.
Combine with Complementary Ingredients
Resveratrol works well in combination with other antioxidants and skin-benefiting ingredients. Consider using it alongside vitamin C for enhanced brightening effects, or with hyaluronic acid for added hydration. However, avoid using it with retinoids or alpha-hydroxy acids in the same application, as this could lead to irritation.

Conclusion
Resveratrol powder is a powerful ally in the quest for healthy, youthful-looking skin. Its ability to boost collagen production, protect against free radical damage, and reduce inflammation makes it a versatile and effective ingredient in skincare. By understanding how resveratrol works and how to use it effectively, you can harness its full potential to achieve glowing, radiant skin.
For more information about resveratrol and other natural herbal extracts, please contact us at information@sxrebecca.com. At Shaanxi Rebecca Biotechnology Co., Ltd., we're committed to providing high-quality, natural ingredients to support your skincare goals.
_1730691017423.webp)



















